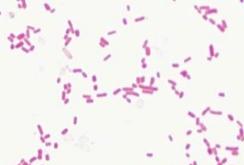

![]()




C O N T E N T S T A B L E O F
Welcome
About the School
Core Facilities
Clinical Trials
Molecular Toxicology
Systems Approaches
Centers

The Office of the Associate Dean of Research and Graduate Studies (ADRGS), led by Manisha Patel, PhD provides full-scope support for all research and sponsored projects coming into the Skaggs School of Pharmacy and Pharmaceutical Sciences. Dr. Patel is the chief research officer and oversees graduate programs in the Skaggs School of Pharmacy and Pharmaceutical Sciences appointed in her role in December 2022 She has been a faculty member at CU Anschutz since 2002 She has provided service and leadership on various institutional committees including serving as Vice-Chair for the School of Pharmacy’s Department of Pharmaceutical Sciences
Dr. Patel received her Ph.D. in Pharmacology and Toxicology at Purdue University, and postdoctoral training in Neuroscience at Duke University. The primary theme of her laboratory's research is to understand the redox and metabolic basis of epilepsy and develop metabolism-based therapies for its treatment
The office of the ADRGS provides full-scope support for all research and sponsored projects coming into the School of Pharmacy and Pharmaceutical Sciences. In addition, The ADRGS office administers several internal funding opportunities, such as the Skaggs Scholars program and internal ADRGS seed grants. We are proud to support over $18 Million in grant funding in the current fiscal year.


UNIVERSITYOFCOLORADO
SKAGGSSCHOOLOFPHARMACYAND
PHARMACEUTICALSCIENCES
The Skaggs School of Pharmacy and Pharmaceutical Sciences has long been ranked a leader in NIH funding among schools of pharmacy and is routinely ranked as one of the most productive research units on the University of Colorado Anschutz Medical Campus. We are pleased to introduce you to our outstanding faculty, research centers and core facilities.
Mission: To transform human health by inspiring and empowering the research enterprise and graduate education in pharmaceutical and clinical sciences, toxicology, and pharmaceutical outcomes
Vision: Offer an outstanding, inclusive environment to advance knowledge and improve health outcomes through research and education.
Find our strategic plan here.
https://pharmacy.cuanschutz.edu/research
Professor and Interim Chair
Department of Clinical Pharmacy

In addition to teaching the next generation of pharmacists and providing exemplary patient care, faculty in the Department of Clinical Pharmacy (DOCP) are also highly engaged in research designed to enhance the safe and effective use of drugs and to assess patient outcomes associated with medication use DOCP faculty conduct clinical research across a wide range of therapeutic areas including oncology, neurology, diabetes, cardiovascular diseases, geriatric medicine, critical care, infectious diseases, and others. The department is also currently developing a new Center for Pharmaceutical Outcomes Research to enhance research in areas such as pharmacoeconomics and cost-effectiveness analysis, pharmacoepidemiology, health policy research, and pharmacy benefits design.

Professor and Chair
Department of Pharmaceutical Sciences
The Department of Pharmaceutical Sciences is a researchintensive department that has long ranked in the top 10% of all schools of pharmacy in both total and NIH-specific funding Our research comprises a unique blend of basic and translational science with an emphasis on drug discovery, development, and delivery. Our faculty address real world problems with a direct impact – such as developing first in class inhibitors for colorectal cancer, tracking the ability of the SARS CoV2 spike protein to evade antibody response, and addressing toxicity in populations exposed to synthetic PFAS contaminants. To support our interdisciplinary brand of science, we host multiple centers and core facilities, and constantly invest in new and emerging technologies. As with our other centers and cores, this instrumentation is available to the Anschutz Campus, the state of Colorado, and the greater Rocky Mountain region. Please reach out to us with any questions – we look forward to hearing from you
Percentile for US schools of pharmacy research dollars
Core Facilities
Research Centers
Major Research Focus areas
Students enrolled in Master’s and PhD programs for Pharmaceutical Outcomes, Pharmaceutical Sciences and Toxicology
Attendees participate school research events each year, including the Annual School Research Retreat, Symposium, Research in Progress and townhalls.
Of lab, research, office, conference and classroom space in the Skaggs School of Pharmacy Building.
In supporting awards from NIH, Foundations, Industry, Skaggs Scholars, internal seed grants, team sciences and collaboration.
Received from The ALSAM Foundation
Gift recently established the Endowed Chair in Translational Research
CU Skaggs School of Pharmacy and Pharmaceutical Sciences faculty offer a range of services for other researchers on our campus and across the globe.
We have state-of-art equipment and our research staff are highly trained individuals who ensure results are accurate and prompt.

The D3SR consists of 4 core facilities working iteratively, including (1) highthroughput discovery sciences featuring state-of-the-art robotic automation and instrumentation; (2) drug design and medicinal chemistry; (3) pharmaceutics; and (4) in vivo pharmacology (DMPK and toxicology).
D3SR Services:
High-throughput Discovery Sciences
Medicinal Chemistry
Pharmaceutics
In Vivo Pharmacology

The Research Pharmacy is the investigational drug resource for clinical research studies
Personalized Support for studies
State-of-the-art clean room
Comprehensive Services
Assures drug studies are conducted in a safe, effective and efficient manner Complies with federal, state and COMIRB regulations concerning investigational drugs.

The CCB provides a wide array of advanced tools and services for computational-based simulations and modeling of chemical and biological systems.
Develop and test hypotheses in silico before executing costly experimental methodologies Reduce the time and costs involved in cutting-edge research.
Provide additional mechanistic justification Aid in the analysis and communication of results

The MS facility utilizes advanced mass spectrometry instrumentation and techniques to assist researchers with their proteomic, metabolomics, and small molecule research.
Proteomics
Metabolomics
Targeted Quantitative Analysis
Small Molecule Research
Hands on Workshops

DanLaBarbera,PhD
Professor and Director, the CU Anschutz Center for Drug Discovery Department of Pharmaceutical Sciences
Education&Training
2001 - BS Biochemistry
2005 - PhD Medicinal Chemistry
2008 - NRSA NIH Postdoctoral Fellow
Multidisciplinary Cancer Research
ResearchExpertise&Interests
HTS/HCS Drug Discovery
Drug Design & Medicinal Chemistry
Cancer Biology & Mechanism of Action
Complex Disease Models (e g organoids)
In vitro & in vivo Pharmacology
OurMission
Be a Colorado hub for drug discovery & development
Provide infrastructure and expertise for drug discovery and development
Harness academic innovation for drug discovery & development
De-risking academic innovation for commercialization
Collaborate with faculty, academic units, and industry to advance academic drug discovery and development

daniel.labarbera@cuanschutz.edu https://pharmacycuanschutz


PhilipReigan,PhD
Professor and Director of Computational Chemistry & Biology Core Facility
Background
A medicinal chemist with >20 years of experience in small molecule drug discovery and development in the pharmaceutical industry and academic settings
Education&Training
BSc in Chemistry, Dept Chemistry, University of Manchester, UK
MSc in Pharmacology, School of Medicine, University of Manchester, UK
PhD in Medicinal Chemistry, School of Pharmacy, University of Manchester, UK
Postdoctoral Fellow, University of Colorado
Focused on the design and chemical synthesis of novel small molecules as candidate therapeutics targeting mechanisms that coordinate between the cell-cycle and metabolism in cancer. Current projects include: DNA damage repair targets (WEE1 kinase, thymidine phosphorylase)
Metabolic reprogramming (AMPK kinase, GSK3β kinase, RSK2 kinase, STAT3/mitoSTAT3) Hypoxia-activated prodrugs



ComputationalChemistry&BiologyCore

Deep-learning workstations that use the Schrödinger platform to perform virtual drug screening, drug design, ligand/protein-protein/DNA/RNA docking, molecular dynamics, predictive ADMET.
philip.reigan@cuanschutz.edu
https://pharmacy.cuanschutz.edu/research/corefacilities/computational-chemistry-and-biologycore-facility
Mass Spectrometry, including metabolomics, lipidomics and proteomics
Nutrimetabolomics and foodomics
Understanding role of host:microbiome metabolism in health and disease


NicholeReisdorph,PhD
Professor and Scientific Director, Mass Spectrometry Facility
Education&Training
BS - Northern State University; Aberdeen, SD (Biology)
MS - University of South Dakota; Vermillion, SD (Biology)
PhD - University of South Dakota; Vermillion, SD (Biochemistry and Molecular Biology)
Postdoctoral Fellow - The Scripps Research Institute, La Jolla, CA (Mass Spectrometry)
Exposomics
Role of oxylipins in inflammatory, immune and lung disease
nichole.reisdorph@cuanschutz.edu
https://pharmacy.cuanschutz.edu/ research/core-facilities/massspectrometry-facility
When collaborating with the Research Pharmacy, you'll be paired with a dedicated lead pharmacist who provides personalized support for your study. They handle both clinical and administrative aspects of drug research, ensuring compliance with federal, state and COMIRB regulations.


SamEllis,PharmD Director of the CU Research Pharmacy

Education&Training
Post-Baccalaureate Doctor of Pharmacy, Oregon State University and Oregon Health Sciences University; Joint Degree
Pharmacy Practice Residency, VA Medical Center, Portland, Oregon
Post-Doctorate Fellowship, Ambulatory Care, University of Colorado Denver
We assist in the execution of the scientific, clinical and administrative functions of drug research.
We assure drug studies are conducted in a safe, effective and efficient manner.
Our team helps you comply with federal, state and COMIRB regulations concerning investigational drugs.
Our faculty participate in a variety of clinical trials, from retrospective chart review to Phase 4 studies with other clinicians from the Anschutz Campus and around the globe. The Faculty work on issues from restless leg syndrome, to treatment of bloodstream infections and psilocybin efficacy on fear in cancer patients

Serves as Principal Investigator for research into CBD and CBG use for Restless Legs Syndrome (RLS)
Co-Principal Investigator for research with psilocybin and cannabis in areas such as Parkinson disease, autism, back pain, depression, post-partum and fear of recurrence while in cancer remission.


JacciBainbridge,PharmD, FCCP
Professor and Vice Chair Research

Multiple Sclerosis Disease Modifying Therapies and other therapeutics
Education&Training
Neurology Residency, University of Colorado (1995 –1996)
Doctor of Pharmacy, University of Colorado (1995) Bachelor of Pharmacy, Ohio Northern University (1988)
Epilepsy, advanced age, refractory polypharmacy strategy, and status epilepticus treatment optimization, transitions of care
Migraine therapeutic plans
Sleep disorders
Movement disorders, Restless Legs Syndrome therapy development, Huntington's disease
PRECEDENTClinicalTrialnetworkwithUniversityof Pittsburgh
Effectiveness of iMIpenem-Relebactam for multidrugˇresistant Pseudomonas AeruGinosa in pnEumonia and bloodstream infections in the United States (MIRAGE)”


MeghanJeffres,PharmD
Associate Professor
Education&Training
Doctor of Pharmacy from the University of Wyoming, Laramie WY
Residency in Pharmacy
Practice at Intermountain
Healthcare, Salt Lake City UT
Residency in Infectious Diseases at Barnes Jewish Hospital, St Louis MO
Ceftazidime-Avibactam versus MeropenemVaborbactam for the treatment of bloodstream infections and/or pneumonia due to carbapenemresistant EnterobacteraLes (CAMEL)

Serve as Principal Investigator and Co-principal Investigator on Phase 1 and Organ Dysfunction Oncology Clinical Trials.


CindyO’Bryant,PharmD
Associate Dean for Academic and Faculty
Affairs, Professor
Education&Training
Doctor of Pharmacy, Mercer University Southern School of Pharmacy (1998)
Pharmacy Practice Residency, University of California San Diego Medical Center (19981999)
Oncology Pharmacy Specialty Residency, University of Colorado Health Sciences Center (1999-2000)
Oncology developmental therapeutics, Organ dysfunction, biological correlates associated with molecular targeted agents, chemotherapy dose modification and pharmacy-managed supportive care issues in cancer treatment.

The center offers biophysical characterization and analysis services for therapeutic macromolecules such as protein and antibody formulations.

Background
The center was founded in 1997 by Drs. John Carpenter and Ted Randolph as a collaborative relationship between the PhD programs in pharmaceutical sciences at the Anschutz Medical Campus and chemical engineering at the CU Boulder campus
ProblemsWeAddress
Native-state assembly energetics and hydrodynamics
Analysis at high macromolecule concentrations
High viscosity studies
Opalescence and phase separation
Thermodynamic stability
Osmotic second virial coefficients
Comparability studies
High-resolution structure and dynamics
Methods
We partner with pharmaceutical biotechnology companies to address contemporary research questions, and the center holds annual Colorado Protein Stability and Aggregation workshops and conferences on issues critical to industry and academic researchers
StateoftheArtInstrumentation
Beckman Optima XLA, XLI, XLF Analytical Ultracentrifuges
900 mHz Varian Nuclear Magnetic Resonance
Spectrometer with cryoprobe
600 mHz Bruker Nuclear Magnetic Resonance Spectrometer
ZetaSizer Helix: Concomitant Raman Spectroscopy/Dynamic Light Scattering
Prota 3S Ultrasensitive Infrared Spectrometer
Chirascan-plus Circular Dichroism Spectrometer with Stop Flow
Formulation – expertise in parenteral, topical, and oral formulations
Liposomes for drug delivery, special emphasis on nucleic acids for tumor treatment
Exosomes – exploiting the exosomal pathway for drug distribution


TomAnchordoquy,BS,MA, PhD
Professor
Education&Training
MA and PhD in Zoology at the University of California at Davis
Postdoctoral Fellow at the University of Colorado Boulder and University of Colorado
Denver

tom.anchordoquy@cuanschutz.edu https://pharmacy cuanschutz edu /research/researchlabs/anchordoquy-lab


DavidBain,PhD Professor
Education&Training
BA, University of Vermont
PhD, Johns Hopkins University
Post-Doctoral, University of Colorado
Our work is focused in two main areas. First, we are interested in the molecular mechanisms of transcriptional regulation using the nuclear receptor superfamily as a model system. We use a blend of biophysical, structural and cell biological approaches to dissect the various protein-DNA and protein-protein interactions critical to transcriptional activation, and then use this information to synthesize and predict overall behavior. Our second focus is on characterizing the molecular interactions of therapeutic proteins, especially at high concentrations and under formulation/delivery conditions. This work is primarily directed toward monoclonal antibodies, but we are also interested in therapeutic peptides and vaccines.

“Designer”Nanoparticles


CarlosE.Catalano, PharmD,PhD Professor
Education&Training
PharmD, University of California, San Francisco, 1983
PhD, Medicinal Chemistry, University of California, San Francisco, 1987


carlos.catalano@cuanschutz.edu
Structure-function of dystrophin in muscular dystrophy
Role of individual domains; Engineering minidystrophins and utrophin for gene therapy
Structure-function of coronavirus spike proteins
Allosteric communication; Effect of mutations; Predicting the next variant
Pharmaceutical biotechnology of protein/antibody therapeutics and AAVs


KrishnaMallela,PhD
Professor, Pharmaceutical Sciences Graduate Program
Associate Director
ResearchCareer
PhD, Tata Institute of Fundamental Research, Mumbai, India (Physical Chemistry)
Postgraduate Researcher, University of California, San Francisco (Biophysics)
Postdoctoral Research
Associate, University of Pennsylvania, Philadelphia (Biophysics)
Research Assistant Professor, University of Pennsylvania, Philadelphia (Biophysics and Biochemistry)
Structure, stability, and aggregation; Excipient interactions; Consultant for multiple pharma companies

Protein structure (CD, fluorescence, NMR, HDX, cryo-EM), binding (ITC, SPR), stability (DSC, chemical/thermal melts), aggregation (SEC, AUC, flow imaging, particle analysis), biophysics (thermodynamics/kinetics), and protein expression/purification.
The Colorado Center for Nanomedicine and Nanosafety promotes collaborative effort, stimulates learning, and advances multidisciplinary research and education in the areas of basic and applied nanomedicine and nanosafety, between academic labs and the local and national biotech and pharma companies.

The CCNN was established within the Skaggs School of Pharmacy and Pharmaceutical Sciences in 2016
The CCNN includes members from University of Colorado Anschutz Medical Campus, other University of Colorado campuses and any other interested, qualifying professionals from the State of Colorado.
Synthesis and evaluation of magnetic nanoparticles, MRI contrast agents, near infrared probes, ultrasound microbubbles, liposomes, PLGA nanoparticles
Toxicity and safety assessment of nanomaterials including cell viability, cellular uptake/dosimetry, cellular and tissue imaging, hyperspectral imaging, biodistribution, inflammatory responses. Small molecule, peptide, protein, and nucleic acid loaded nanoparticles for enhanced drug/gene delivery; ligand functionalized nanoparticles for targeted delivery; pure drug nanoparticles and nanotubes; polymeric, protein, and viral capsid nanoparticles
Lead the discovery of new diagnostics and therapeutic approaches that can be translated and commercialized
Provide intellectual, technical and financial resources in the research and service areas of nanotechnology and nanomedicine.
Promote the penetration of nanomedicine and nanosafety into clinical and translational research.
Increase the awareness of safety and toxicity issues associated with nanomaterials and the role of environmental nanomaterials in the pathology of disease
The CCNN will provide training and education of clinical and basic scientists
Fiber optic based near infrared spectroscopy system (FONIRS) 2 NIR wavelengths
CytoViva Enhanced Darkfield Hyperspectral Microscope
Malvern Zetasizer
Perkin Elmer ICP-MS with HPLC and single cell/nanoparticle capability
Guava flow cytometer with high throughput capability
JaredBrownLab:InductivelyCoupledPlasmaMass Spectrometry(ICP-MS)
We can measure elemental concentration (e.g., metals) Also perform single particle analysis Provides nanoparticle size, number, concentration


JaredBrown,PhD
Professor Toxicology
Graduate Program Director, T32 Training Program in Molecular and Systems Toxicology Director, Colorado Center for Nanomedicine and Nanosafety Co-Director

https://pharmacy.cuanschutz.edu/ research/researchlabs/immunotoxicology-lab
Drug formulation
Long-acting drug delivery system preparation (implants, microspheres, gels, and nanoparticles)
Drug quantification in samples of various types including tissues using LC-MS/MS
Drug delivery and pharmacokinetic assessment


UdayKompella,PhD
Colorado Center for Nanomedicine and Nanosafety Co-Director and Co-founder, Professor
ResearchCareer
PhD (Pharm. Sci.) – University of Southern California, Los Angeles, CA
MPharm (Pharm Engg ) –Jadavpur University, Kolkata, India
BPharm (Hons) – BITS, Pilani, India

uday kompella@cuanschutz edu
https://pharmacy.cuanschutz.edu /research/researchlabs/nanomedicine-and-drugdelivery-lab
Iron oxide nanoparticles for MRI
Immune response for population
Immune clearance
Biodistribution and tumor targeting of lipid nanoparticles
RBCs and exosomes as drug carriers
Accumulation of nanoparticles in skin


DmitriSimberg,PhD
Professor, Colorado Center for Nanomedicine and Nanosafety Co-Director
Ph.D. in Biochemistry from the Hebrew University of Jerusalem.
Postdoc 1: Targeted Nanomedicine at the Burnham Institute
Postdoc 2: Ultrasound imaging, Department of Radiology, UCSD.
Author or co-author on ~100 research papers, reviews, perspectives, and book chapters.
Federal funding > $15 million
Trained ~30 undergraduate, graduate and postdocs

dmitri simberg@cuanschutz edu
https://pharmacy.cuanschutz.edu/ research/researchlabs/translational-bionanosciences-lab
The vision of CePOR is to foster and grow education and research excellence in three primary disciplines: pharmacoepidemiology, pharmacoeconomics, and pharmaceutical and drug related policy.

CePOR faculty have an extensive record of successful collaborations with the School of Medicine, Adult and Child Consortium for Health Outcomes Research and Delivery Science (ACCORDS), Colorado School of Public Health, the Colorado Clinical and Translational Sciences Institute (CCTSI), and the Center for Bioethics and Humanities These exciting and progressive collaborations bring together a diverse, multidisciplinary, highly experienced group of talented clinicians and researchers.
The Colorado Consortium for Prescription DrugAbusePrevention
Works with partners to focus efforts to advance Colorado’s opioid crisis response.
Coordinates our state’s response to the crisis of misuse and abuse of prescription medications such as opioids (including fentanyl), stimulants, and sedatives

Pharmaceutical Value Initiative (pValue) and Institute for Clinical and Economic Review collaboration
Aims to apply and test novel methods for value assessment that encourages stakeholder engagement and promotes value-based decision making.
Investigating Patient utilization in CO Managed Care Evaluation of Opioid effects on Medicaid members
RockyMountainMultipleSclerosisCenterand theMemoryDisordersClinicforthetreatment ofAlzheimer’sDiseaseandRelatedDementia
https://pharmacy.cuanschutz.edu/research/research-centers/center-for-pharmaceutical-outcomes-research
We conduct retrospective, prospective, and concurrent drug utilization review of pharmacy and medical claims for Health First Colorado members.


HeatherAnderson,PhD
Associate Professor, Director of Assessment and Outcomes
We prepare modules on different topics, producing one final module and one draft module each quarter. Each module includes a set of analyses designed to provide evidence to inform prior authorization criteria for therapeutic classes and specific medications as well as possible educational interventions for broad therapeutic issues (e.g., letters to providers and online and peer-topeer education) for the provision of safe, cost-effective drug therapy throughout the state.


Education&Research
MS in Biostatistics
PhD in Epidemiology
15 years with SSPPS
Research focuses on Colorado
Medicaid DUR, PGx, mental health treatment, and scholarship of teaching and learning
We use electronic health record data and genetic data for UCHealth patients in the CCPM biobank to evaluate the implementation of clinical pharmacogenomics within the UCHealth system.
We have also collaborated on a series of analyses that leveraged paid medical and pharmacy claims to describe the use of single-gene pharmacogenomic testing in a U.S. managed care population, describe the use of single-gene pharmacogenomic testing in depressed patients in a U.S. managed care population, and to describe amount of exposure to pharmacogenomic drugs for patients in a U.S. managed care population.
Dr. DiStefano’s research is primarily focused on health technology assessment, prescription drug policy, and direct-to-consumer pharmaceutical advertising.
He is particularly interested in the ethical considerations that arise in each of these research areas.
To advance research in these areas, Dr. DiStefano draws on both empirical research methods and conceptual and normative analysis.


MichaelDiStefano,PhD
Assistant Professor
Education&Research
PhD, Health Policy, Johns Hopkins Bloomberg School of Public Health (2021)
M Bioethics, University of Pennsylvania (2014)
AB, Religion, Princeton University (2011)
His work has been published in JAMA, Health Affairs, and Value in Health.

michael.j.distefano@cuanschutz.edu
Research in comparative effectiveness research, costeffectiveness applications and methods development, value-based outcomes contracting, and patient preferences research.
Active in health economics-related societies such as the International Society for Pharmacoeconomics and Outcomes Research (ISPOR) through contributions to ISPOR short courses, workshops, issue panels, and research presentations.


R.BrettMcQueen,PhD Associate Professor
Education&Research
PhD in Pharmacoeconomics, University of Colorado, Denver
MS in Economics, University of Colorado, Denver
BA in Economics, University of Colorado, Boulder
Serves on multiple dissertation committees in the Pharmaceutical Outcomes Research PhD program. Director of the Center for Pharmaceutical Value (pValue), exploring multi-criteria decision analysis (MCDA) for health care decision making.
Served in a PhRMA Foundation Postdoctoral Fellowship in Health Outcomes at SSPPS and most recently was a Health Economist and Researcher with the Research in Real Life (RiRL)/Observational and Pragmatic Research Institute (OPRI) located in Cambridge, United Kingdom.
Primary research interests lie in evaluating the treatment of neurological diseases.
Examining the comparative effectiveness of disease modifying agents used in the management of multiple sclerosis, myasthenia gravis and neuromyelitis optica spectrum disorder using a combination of several measures to include brain atrophy measurement, clinical cognition, blood biomarkers and patient reported outcomes.


KavitaNair,PhD,FAAN Professor
Education&Research
PhD in Pharmacy
Administration, University of Michigan
MS in Pharmaceutics, University of Toledo
BPharm, University of Delhi, India
Other areas of interest involve improving access related issues and assessing the disruption in care for patients with neurological conditions taking infusible agents through collaborations with the Colorado legislature in policy creation and with payers in developing model policy coverage.
Serves as Chair of the Coding and Payment Policy Subcommittee and member of the Medical, Economics and Practice Committee of at the American Academy of Neurology. Also a member of the Executive Council of Brain PAC for the American Academy of Neurology. Serves as the Vice Chair for the Board of Directors for the Center for Improving Value in Health Care- the administrative group that managed the Colorado All Payer Claims Database.
Pharmacoepidemiology and drug safety
Emphasis on psychotropic medications; examples: Antidepressants and suicide related behaviors
Antipsychotics and metabolic disturbances
Opioids and use disorders, overdose, overdose deaths
Prescription Drug Abuse Prevention
Established Center for Prescription Drug Abuse
Prevention


RobertValuck,PhD,RPh
Professor and Executive Director of the Center for Prescription Drug Abuse Prevention
Education&Research
PhD in Pharmacy
Administration, University of Illinois at Chicago
MS in Pharmacy
Administration, University of Illinois at Chicago
BS in Pharmacy, University of Colorado
Coordinate statewide efforts for research, education, policy, and prevention relating to the opioid/fentanyl crisis

Academic and external investigators working in preclinical and clinical development of drugs and biologics, or conducting independent research, can contact Center members directly for opportunities to collaborate and develop appropriate strategies for integration of pharmacokinetics, pharmacodynamics and pharmacogenetics.


Background
The center is a collaborative group of pharmacokinetics and pharmacogenomics experts with the scientific and technical expertise, knowledge, and physical resources to conduct high-level translational research in these fields
Terms
Pharmacokinetics: the study of the time course of absorption, distribution, metabolism, and excretion (i.e., disposition) of drugs in the body. Pharmacodynamics: the study of the relationship between drug concentrations and drug response in the body.
Pharmacogenomics: the study of how genetic variation influences interindividual variability in drug disposition and response
Equipment
HPLC with UV, Fluorescence, PDA
LC-MS (ThermoScientific MSQ)
LC-MS-MS (ThermoScientific TSQ Quantum)
UPLC-MS-MS (ThermoScientific Accela-TSQ Vantage)
Biotage Primer Design Software
PHASE (for haplotype analysis)
Focus: The study of antiviral drug disposition in humans and how this relates with clinical outcomes.
Pharmacokinetic analyses
Bioanalysis in biofluids and cells
Pharmacokinetic study designs
Stable-labeled isotope tracing
Regulatory experience


PeterAnderson,PharmD Professor
Education&Research
BS Biology University of Minnesota 1991
BS Pharmacy University of Minnesota 1997
PharmD University of Minnesota 1998
Antiviral pharmacology
fellowship University of Minnesota 2001 (Advisor Courtney Fletcher)
Faculty University of Colorado 2002-present


https://pharmacy cuanschutz edu/ research/research-labs/coloradoantiviral-pharmacology-lab
Pharmacogenomics and personalized/precision medicine
Evaluation of the clinical impact, value, and sustainability of large-scale clinical pharmacogenomics implementation initiatives, with a major focus on the UCHealth system Development and evaluation of novel tools to guide patient selection and maximize the benefit of pharmacogenomics and personalized medicine

ChristinaAquilante, PharmD
Professor, Endowed Chair in Translational Pharmaceutical Sciences Director of Pharmacogenomics for the Colorado Center for Personalized Medicine
Education&Research
PharmD with Honors and Distinction, University of North Carolina at Chapel Hill (2000) Residency, University of Florida (2001)
Research Fellowship in Pharmacogenomics, University of Florida (2003)
Graduate Certificate in Clinical Science, University of Colorado, Anschutz Medical Campus (2008)
christina aquilante@cuanschutz edu
Informing and optimizing safe and effective medication use through pharmacokinetics
Specialized focus in HIV and other related co-infections (i.e., tuberculosis, hepatitis B/C, COVID-19, mpox), pediatrics, pregnancy, and persons with alcohol and/or substance use disorders
Pharmacokinetic study design, analysis, and modeling approaches for studies ranging from pilots to large-scale, international studies


KristinaBrooks,PharmD
Assistant Professor
Education&Research
B.S. Neuroscience , University of Michigan (2011)
PharmD. University of Michigan (2015)
Postdoctoral Fellowship, Clinical Pharmacokinetics
Research Unit, Clinical Center
Pharmacy Department
Postdoctoral Fellowship
Department of Pharmaceutical Sciences, University of Colorado Skaggs School of Pharmacy and Pharmaceutical Sciences
Developing novel bioanalytical methods for quantifying drugs and other moieties in human blood and tissue samples

What do the drug exposures look like in the target population? What factors affect drug disposition?
How does PK relate to treatment outcomes? Are alternative dosing strategies needed to optimize these outcomes?
How does PK relate to safety outcomes? Are there ways to mitigate side effects?
Can we develop or modify objective, PK-based measures of adherence?
The Joy laboratory specializes in applying pharmacology, pharmaceutical sciences and toxicology research techniques to drug development of small molecules and biologics. We also employ delivery approaches and study of new technologies, including medical devices and diagnostics. Below outlines areas of research.
PreclinicalandClinicalTherapeuticDevelopment
The goal of research under this program is to discover and develop novel drugs, diagnostics and devices for kidney diseases. Current research includes 1) a novel device for reducing the burden of hyperphosphatemia in End Stage Kidney Disease, 2) novel drugs and drug delivery strategies, and 3) repurposed drugs for kidney diseases. The lab conducts testing of novel compounds to determine the preclinical efficacy, toxicity, and PK profiles.

MelanieJoy,PharmDPhD
Professor Director of Innovation and Commercialization, Director of Entrepreneurship
Education, SPARK/REACH
Program, Director of the Center of Excellence
Program for Model Informed Drug Development
Education&Research
PhD (Pharmaceutical Sciences
- Molecular Pharmaceutics) University of North Carolina, Chapel Hill, NC
Postdoctoral Fellowship
Training: University of Pittsburgh PharmD, Duquesne University, BS Pharmacy, University of Pittsburgh,
Omics approaches are used for the discovery and profiling of novel biomarkers for kidney toxicity and diseases. Current studies are utilizing approaches such as Somamer technology and kidney injury panels.
The Joy lab’s research bridges the basic science to clinical science to enhance the translational potential for reducing the burden of kidney injury due to medications. Specific areas of emphasis are 1) mitigation of kidney injury, 2) role of drug metabolism and transport in nephrotoxicity, 3) role of pharmacogenomics in kidney injury.
BioinformaticsUtilizingElectronicHealthRecordandGenetic Biobank
A current study is evaluating clinical and electronic health record risks and profiles of various phenotypes of druginduced kidney injury.
PreclinicalandClinicalPharmacokineticsand Pharmacodynamics
The Joy lab conducts preclinical and clinical pharmacokinetic and pharmacodynamic modeling and simulation. These techniques have been used in the lab to study the relationship between drug levels and biomarkers of kidney injury response.
melanie.joy@cuanschutz.edu
https://pharmacy cuanschutz edu/ research/research-labs/kidneydisease-pharmacology
The goal of the lab is to investigate the genetic underpinnings of reduced sensitivity to alcohol, a wellestablished contributor to alcohol use disorders (i.e., alcoholism, binge drinking). An example of our work is the identification of histone deacetylase 1 (Hdac1), a broad regulator of gene expression, as one of likely many genes that contribute to genetic variation in alcohol sensitivity.


RichardRadcliffe,PhD Professor
Education&Research
BS in Biology (Va. Tech, 1984) PhD in Neuropharmacology under Dr V Gene Erwin (UCHSC, 1996)
Postdoctoral fellowship under Dr Jeanne Wehner (Institute for Behavioral Genetics, UCB, 1996-99)
Postdoctoral training under Dr. Richard Deitrich (CU Anschutz, 1999-2001)
Faculty, CU Skaggs School of Pharmacy and Pharmaceutical Sciences, 2001-present)
Sabbatical training, Deep Sequencing Computation and Analysis, BioFrontiers Institute (Dr. Robin Dowell)
QTLmappingoflossofrightingresponseacute tolerancepinpointsHdac1asacandidategene.

Cis-regulationofHdac1influencestheexpressionof manyothertrait-relevantgenes.

Geneexpressionsignaturemappingdemonstratesthat alcohol-dependentalterationsinbraingeneexpression isverysimilartoalteredpatternsofgeneexpression causedby17differenthistonedeacetylaseinhibitors.

Specific Disease Area - Genetics of Substance Use Disorders (Alcohol, Oxycodone, Cannabis)
Collaborations - Advanced statistical applications including omics and high-dimensional data across a wide variety of disease areas
Methods/Software Development - Multi-omics network, quantitative genetics, transcriptomics informatics, and general omics methods development


LauraSaba,PhD
Associate Professor, Pharmaceutical Sciences
PhD Program Director
Education&Research
PhD in Biostatistics (University of Colorado Health Science Center)
BS in Chemistry (Colorado School of Mines)
Appointments/Affiliated with Secondary Appointment in Department of Biostatistics and Informatics (CSPH)
Graduate Program
Membership in: Pharmaceutical Sciences, Toxicology, Pharmaceutical Outcomes, Computational Biosciences, Pharmacology, Biostatistics
Fellow at the Institute for Behavioral Genetics at CU Boulder
Educational Approaches – basic statistics / data science / quantitative genetics / omics statistics / high-dimensional data
Outreach Area of Interest – medical research career exploration/exposure for rural / under resourced students (undergraduates and high school students)
Molecular toxicology focuses on elucidation of molecular mechanisms of toxicity of drugs and pollutants, and includes metabolic, pharmacogenomics, proteomic and metabolomics approaches. These techniques allow studies of individual susceptibility and isolation of predictive biomarkers of toxicity.

AreasofResearchFocus
Alcohol Liver Disease
Autoantigen discovery
Behavioral Responses
Bladder Cancer
Cancer Biology
Cancer Pharmacology
CAR-T
Cytochrome P450 enzymes
Drug Metabolism
Engineered T Cell therapies
Enzymology
Epilepsy
Immunotherapy
Kidney Disease
Mitochondrial dysfunction
Natural Immunosuppression
Neurodegeneration
Post-translational modifications
Quantitative RNA sequencing
Systems genetics
Warfare Vesicants
https://pharmacy.cuanschutz.edu/pharmaceutical-sciences/research-areas/molecular-toxicology
Cancer Pharmacology, Cancer Mechanisms, Cancer Prevention, Toxicology of Chemical Warfare Agents and Developing Therapeutics/Drug-repurposing.
Cancer and role of phytochemicals in its prevention and treatment
Vesicant-induced toxicity and therapeutic development


RajeshAgarwal,PhD
Professor
Education&Research
PhD in Bio-organic chemistry from Lucknow University (1981)
UCCC Cancer Prevention and Control Program Co-Leader (2009-2023)
Interim Chair DOPS (20222023)
CAR T and engineered T cell therapies of autoimmune diseases
Mechanisms of T cell mediated metal hypersensitivities
Mechanisms of T cell recognition of autoantigens in Type 1 diabetes and RA
Redox signaling and drug design in the immune diseases and infectious diseases


ShaodongDai,PhD
Professor
Education&Research
B.E., Beijing University of Chemical Technology, China (Biochemical Engineering) PhD, Uppsala Biomedical Centre, Sweden (Molecular Biology)
Post-doctoral Fellow, Purdue University (Structural Biology)
Quantitative analysis of post-translational modifications using novel mass spectrometry techniques
Antibody-based enrichment and click-chemistry targeted assays to study lysine acylation and thiol redox
Mechanistic study of metabolically-derived kidney and liver diseases
Understand how sirtuins impact protein function in nuclear, cytosolic, and mitochondrial processes


KristoferFritz,PhD
Associate Professor, Graduate Program in Toxicology
Education&Research
BS, La Sierra University, Riverside, CA (Biochemistry)
PhD, Loma Linda University, Loma Linda, CA (Biochemistry)
Postdoctoral Fellow, University of Colorado
Leverage artificial intelligence for biomarker discovery
Apply machine learning and artificial intelligence to enhance therapeutic intervention for liver disease
Expertise: Analytical biochemistry, bioinformatics, spatial transcriptomics, artificial intelligence, virtual reality, proteomics, post-translational modifications, alcoholassociated liver disease, sirtuin activity, and mitochondrial biology
Principal investigator, educator, and scientific leader in the ADME/DMPK field


JedLampe,PhD
Associate Professor
Education&Research
Post-doctoral Fellowship in Pharmaceutical Chemistry, University of California, San Francisco
PhD in Medicinal Chemistry, University of Washington
MS in Microbiology, Idaho State University
BS in Biological Sciences, Walla Walla University
Research interests involve the application of bioanalytical, biophysical, and computational techniques to understand and predict drug metabolism and disposition in special population groups including: neonates, pregnant individuals, cystic fibrosis patients, and those exposed to the ubiquitous environmental toxicant PFAS R01 funded projects currently include: 1) PBPK modeling of drug-hormone interactions during pregnancy and 2) defining the function of cytochrome P450 enzymes in Pseudomonas aeruginosa to fight antimicrobial resistance

Mechanistic Toxicology
Tissue-resident Immune Monitoring and Profiling Complement- and Immune-mediated Disease
Preclinical Models of Environmental and Lifestyle
Exposures: Obesogens, Western Diet, Alcohol


RebeccaMcCullough,PhD
Assistant Professor, Toxicology Graduate Program Associate Director
Education&Research
Research Associate: Inflammation and Immunity, Cleveland Clinic
Postdoctoral Fellowship: Inflammation and Immunity, Cleveland Clinic
PhD: Toxicology, University of Colorado Anschutz Medical Campus
BS: Biology and Chemistry, Northern State University


Environmental causes of neuronal injury
Mitochondrial (dys)function and oxidative stress in epilepsy and neurodegeneration
Neuroinflammation and redox signaling
Redox-based small molecule therapeutics


ManishaPatel,PhD
Professor, Associate Dean of Research and Graduate Studies
Education&Research
PhD: Neurotoxicology (Purdue Univ)
Postdoc: Neuroscience (Duke Univ)
NIH funding: R37039587, R01HD21007

https://pharmacy.cuanschutz.edu /research/research-labs/patel-lab
Investigation of how an exposure to a single environmental agent, such as the fungicide maneb, augments the transport and cytotoxic properties of pharmaceuticals, dietary components, and/or chemicals arising from the environment or microbiome
Elucidation of these mechanisms will help to prevent exacerbated toxicity due to alterations in gene expression resulting in enhanced transport of toxicants and xenobiotic interactions


JamesRoede,PhD Associate Professor
Education&Research
BS, Michigan State University
PhD, University of Colorado (Advisor, Dennis R. Petersen) Postdoctoral Fellow, Emory University (Mentor, Dean P. Jones)
This mechanism may be directly relevant to neurodegenerative diseases like Parkinson’s disease and neurodevelopmental diseases like autism
The aim of the laboratory is to utilize both targeted and systems approaches, such as proteomics, metabolomics and epigenomics, to investigate mechanisms of toxicity
Research Interests:
Environmental causes of neurodegeneration e.g. maneb exposure
Metabolic consequences of mitochondrial dysfunction
Proteostasis and neurodegeneration
Thiol redox dysregulation in mechanisms of toxicity
These resources facilitate biomarker analysis and allow complete analysis of metabolomics and proteomic changes associated with drugs and toxicants.





ThomasDelong,PhD Associate Professor
Education&Research
PhD in Chemistry/Biochemistry
Department of Biochemistry
University of Erlangen
Nuremberg, Germany
Postdoctoral Fellow in Immunology Department of Immunology and Microbiology
University of Colorado Denver
Hybrid Insulin Peptides (HIPs) are autoantigens in Type 1 Diabetes (T1D) formed when proinsulin fragments covalently bond with other beta-cell peptides (Figure 1). These HIPs contain unique amino acid sequences not expressed in the thymus, allowing HIP-reactive T cells to escape negative selection and subsequently target pancreatic beta cells. We identified the enzyme Cathepsin D (CatD) as responsible for creating disease-relevant HIPs in pancreatic islets of both humans and NOD mice. Furthermore, our research indicate that elevated glucose levels and innate cytokines promote HIP formation by lowering insulin granule pH and activating CatD (Figure 2). This may allow HIP reactive T cells to mediate beta-cell destruction in response to environmental stressors. Importantly, when stressors subside, HIP formation decreases, supporting a multi-trigger model of T1D pathogenesis and establishing a direct link between environmental factors and autoimmunity (Figure 3). A deeper understanding of HIP formation mechanisms could lead to novel targeted interventions for T1D.



By 2050: 50 million deaths due to antimicrobial resistance
There is an incongruence between in vitro antimicrobial sensitivity testing and treatment efficacy due to metabolic cooperation between co-infecting microbes. We develop and apply novel approaches to elucidate the molecular mechanisms governing the chemical interactions of co-occurring microbes in humanassociated microbiomes to discover new therapeutic strategies for antimicrobial resistance and tolerance.


VanessaPhelan,PhD
Associate Professor
Education&Research
B.S. – University at Albany, SUNY Biochemistry and Molecular Biology
Ph.D. – Vanderbilt University
Chemistry
Postdoctoral Fellow –University of California, San Diego

Hypothesis: VIS induced by neurotropic viruses of the central nervous system is a mechanistic driver of accelerated aging and degenerative processes of the brain.


JulioAguado,PhD
Assistant Professor
Education&Research
PhD in Systems Medicine 2013 - 2018 European School of Molecular Medicine, University of Milan, Italy
Postdoctoral Research Fellow 2018-2024 The University of Queensland, Brisbane, Australia

Our research interests are radiobiology, tumor microenvironment and metabolism


GinaBouchard,PhD
Assistant Professor
Education&Research
BS Pharmacology, University of Sherbrooke, Canada.
PhD Radiation Science and Biomedical Imaging University of Sherbrooke, Canada
Postdoctoral fellowship
Stanford University



We are an interdisciplinary team dedicated to unraveling how proteins regulate mitochondrial homeostasis in both healthy and diseased cells. Our ultimate goal is to develop innovative drugs that enhance human health.


BlakeHill,PhD Professor and Chair Education&Research
The CU Anschutz Medical Campus welcomed Dr. Hill in January of 2024 where he continues his work researching mitochondrial homeostasis In 2000, Dr Hill joined the faculty at Johns Hopkins University, where he began his NIH-funded research program on the molecular basis of mitochondrial homeostasis. His postdoctoral training in protein design and engineering was completed at the University of Pennsylvania School of Medicine where he was awarded NIH and George W. Raiziss fellowships.
PhD from Yale University (Biophysical Chemistry) in 1995
BS from Kalamazoo College,
Our research primarily targets proteins involved in mitochondrial fission and fusion, as well as those interacting with mitochondria during apoptosis. We have pioneered a first-in-class inhibitor and are currently testing its effects in various disease models.
Our work not only advances drug discovery but also deepens our understanding of the fundamental biology, chemistry, and physics of protein-protein and protein-membrane interactions. These interactions are crucial for the signaling pathways that play a significant role in human diseases.


